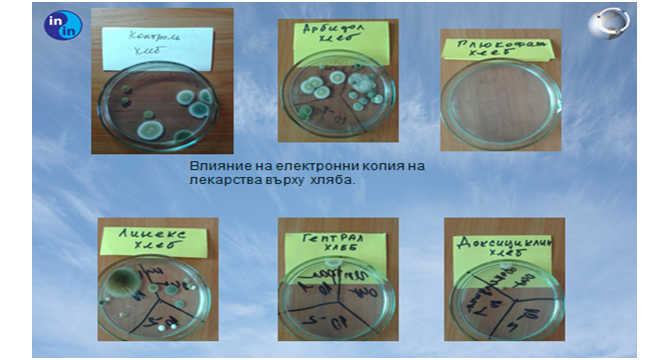

Български принос в изследванията на „Чудото“ за преноса на IC - информационни копия

(виж целия протокол)
Бяха изследвани показатели като P / H, киселинност, плътност, индекс на рефракция (пречупване на светлината), съдържание на полифеноли във вино. Получените резултати способстват за по-доброто разбиране на процесите на въздействие на информационните копия, а натрупания опит и нови знания потвърждават по-ранни изследвания за процесите на предаване на информационни копия на различни вещества, проведени от световно известните учени Жак Бенвенист и Люк Монтание.
Преди години Професор Монтание доказва възможността за трансфер на IC копие на ДНК клетка в контролна проба вода, която съдържа необходимите ДНК компоненти, ензими и нуклеотиди. Компонентите в тестовата проба вода са в несвързано състояние.
В резултат на прехвърляне на информацията на ДНК клетката в пилотна проба на вода, се наблюдава подреденост и свързаност на компонентите така, че съставът е идентичен с този на „оригинала“. Тоест във водата се сформира пълноценна ДНК, абсолютно копие на „оригинала“.
Българската практика доразвива тези изследвания. В проведените в България изследвания се наблюдават интересни резултати, които се обясняват с въздействието на различни IC информационни копия на отделни химически вещества, като съставка на определени фармацевтични продукти.
Например IC копията на „OMEZ“ и „ALLOPURINOL“ водят до ефект на намаляване на киселинността в стомаха и урината, като същият ефект се наблюдава при измерване на киселинността в напитка кока кола. Използвани са информационни копия на посочените субстанции, които се съхраняват в специален отдалечен технически център, посредством връзка през интернет.
Много интересни са резултатите от въздействието на IC копия при виното. Следствие на въздействието, стойността на полифенолите (антиоксидантите), в зависимост от използваното IC информационно копие, се променят. Стойността на полифенол е един от показателите, определящи качеството на виното.
Ако се вгледате в графиката на промяната на полифеноли в съдържанието на виното след въздействие с информационни копия (IC), ще ви направи впечатление, че след въздействие с „GLUCOPHAGE“, стойността пада до 1.6, а след въздействие с IC на „HEPATRAL“ се увеличава до 4.0.

Очевидна е в този случай и аналогията с експеримента на Люк Монтание. Несвързаните атоми и полифенолни молекули, под влиянието съответните IC информационни копия, в по-голяма или в по-малка степен се свързват и образуват или полифенолно съединение или се разпадат и стават свободни (несвързани).
Необходимо е също така да се припомнят и заключенията на Проф. Суринов – доктор на биологическите науки, следствие на проведен експеримент за въздействие с IC копия, върху групи мишки. Получените данни показват, че при въздействие с IC копия на „ARBIDOL“ и „DEXON“, се променя способността да се стимулира или потиска имунната реакция на лабораторните животни. IC копие на „ARBIDOL“ увеличава броя на клетките, отговорни за имунната система, както и обратното, „DEXON“ ги намалява. Същото се наблюдава и при изследванията върху плесен. В зависимост от третиране с отделните IC копия, клетките на плесента спират да се развиват или рязко увеличават развитието си.
В подкрепа на тези проучвания и заключенията от тях, можем да посочим и резултатите от проучванията за въздействието върху пчелен мед, пилешко месо и сметана.

Това изследване е проведено от доктора на химическите науки Донка Христова независимата акредитирана лаборатория „ПЕЛАС КОНСУЛТ“ . Използвани са IC информационни копия от отдалечен технически център, като достъпа се осъществява през интернет.
При третиране с IC копия на различни вещества, в отделните продукти се наблюдава или повишение на концентрацията на вода, тоест образуване на допълнителни водни молекули или обратен ефект намаляване на водните молекули.
Такива примери има много, но едва сега става ясен механизма на въздействие чрез IC копия.
Изследванията, правени във Франция, Русия и България показват един и същ модел на „отговор“ в природата, че следствие на въздействие с IC копия се създават или разпадат молекули, активират се или се разпадат клетки.
Интересното е, че в състава на „ХЕПАТРАЛ“ влиза като спомагателно в-во колоиден силициев диоксид. Това вещество се използва в почти всички лекарства за лечение на стомашно-чревния тракт.
Полупроводниковите свойства на SiO2 (силициевия диоксид) позволяват пренос на електрони между него и ко-реагентите, които в този случай са полифенолни молекули. Следствие на това беше интересно да се сравни как ще се отрази на стойностите на полифеноли, въздействието с IC информационни копия на отделните активни вещества и на отделните спомагателни вещества. Но тази информация е обект на по-нататъшни изследвания.
Дали там е тайната на трансформацията? Може би сме на прага на обяснение на необясними все още чудеса, като например превръщането на водата във вино преди 2000 години…
Преносът на IC информационни копия отваря безкрайни възможности за практическото им използване.
Марина Логвиненко - Рефлексолог,
Директор на Възстановителен център "Хармония"
гр. Бургас
ИЗТЕГЛИ БЕЗПЛАТНО ИНФОРМАЦИОННО КОПИЕ ОТ ТУК!
прочети още Инж. Евгени Германов за технологията IC Medicals
прочети още Как чаша вода става информационно копие на лечебни средства?
прочети още Лечение с информационни копия. Какво и как лекува информираната вода?
прочети още Стартира уеб платформа за информационни копия на вещества
научи повече за технологията в рубриката IC Medicals- Информационни копия
Още от "Изследвания и резултати"
![]() Възможностите на водата за възпроизвеждане на IC - информационни копия на биологично активни вещества (част 6)Сравнителни проучвания за ефективността на информационните технологии и по-специално за прехвърлянето на IC копия на отделни химични вещества. ...още |
![]() Възможностите на водата за възпроизвеждане на IC - информационни копия на биологично активни вещества (част 5)Устойчив положителен ефект се постига след 4 седмици прием на вода. При анализа на лабораторните данни не са открити статистически значими разлики и в ...още |
![]() Възможностите на водата за възпроизвеждане на IC - информационни копия на биологично активни вещества (част 5)Устойчив положителен ефект се постига след 4 седмици прием на вода. При анализа на лабораторните данни не са открити статистически значими разлики и в ...още |
![]() Възможностите на водата за възпроизвеждане на IC - информационни копия на биологично активни вещества (част 4)Целта на изследването е да се проучи ефекта на водата с емисия на Arbidol върху превенцията на вирусна инфекция при доброволци (студенти). ...още |